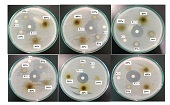
Cover Image

|
ALCHEMY Jurnal Penelitian Kimia is a peer-reviewed, open-access journal publishes original research articles or review articles both theoretical and experimental studies on all aspects of fundamental and applied chemistry, including organic, inorganic, analytical, physical, computational chemistry, sustainable, green, and environmental. ALCHEMY Jurnal Penelitian Kimia covers studies in emerging fields of current innovative chemistry. Moreover, ALCHEMY Jurnal Penelitian Kimia pays special attention to the studies related to the exploration research of minerals and natural materials, including plant extracts that grow in Southeast Asia. ALCHEMY Jurnal Penelitian Kimia published twice a year in March and September.
|
|||||||||
Announcements
| No announcements have been published. | |
Vol 22, No 1 (2026): March
This issue has been available online since 31 March 2026 for the regular issue of March 2026. All articles in this issue (19 original research articles and 3 review articles) were authored/co-authored by 105 authors from 38 affiliations and 3 countries
(Indonesia, Malaysia, Republic of Korea)
Full Issue
| View or download the full issue | Front Matter |
Table of Contents
Review Articles
|
Sevi Dwi Cahyani, Triana Kusumaningsih, Maulidan Firdaus, Wahyu Eko Prasetyo
|
1-39
|
|
|
Tian Puspita Sari, Fitri Khoerunnisa, Asep Kadarohman
|
40-59
|
|
|
Nurina Rizka Ramadhania
|
60-73
|
Research Articles
|
Arnees Angzora, Athena Lilavya Putri, Johanna Felicia Susanto, Kathlia Putri Alyanisa, Debian Mydea Erliputeri, Nawadhir Fauzan, Shela Salsabila, Muchtaridi Muchtaridi
|
74-87
|
|
|
Eka Putra Ramdhani, Hilfi Pardi, Nola Ritha
|
88-94
|
|
|
Dhian Eka Wijaya, Afra Raeviana Putri, Intan Lestari, Edwin Permana, Munifilia Ekasari, Nur Ahniyanti Rasyid
|
95-105
|
|
|
Fastabiqul Khoirot, Muhammad David Julian Syach, Sentot Budi Rahardjo, Triana Kusumaningsih
|
106-116
|
|
|
Jufrizal Syahri, Rahmiwati Hilma, Nurlaili Nurlaili
|
117-126
|
|
|
Alifiani Maulida, Gusrizal Gusrizal, Anis Shofiyani
|
127-137
|
|
|
Agung Abadi Kiswandono, Anisa Rahmawati, Yanesta Oxvyena, Purna Pirdaus, Sonny Widiarto, Sutopo Hadi, Rinawati Rinawati
|
138-147
|
|
|
Dian Eka Ermawati, Nur Cahyo Fajar Trihantono, Ulfa Afrinurfadhilah Darojati, Nindita Claurisa Amaris Susanto, Sholichah Rohmani, M. Fiqri Zulpadly, Annisa Diyan Meitasari, Diyah Tri Utami, Anif Nur Artanti, Heru Sasongko, Meta Kartika Untari
|
148-156
|
|
|
Asri Azizah, Diana Triyanti, Putri Sahira, Anisa Putri, Retno Sulistyo Dhamar Lestari, Jayanudin Jayanudin
|
157-169
|
|
|
Eka Sri Yusmartini, Mardwita Mardwita, Eko Ariyanto, Wahyu Triaji Rahadianto, Ikbal Oktaviansyah, Muhammad Dzaky Muzhaffar
|
170-178
|
|
|
Nelly Suryani, Rachmadi Wibowo, Rosa Adelina, Vivi Anggia, Tania Sabarini, Sabrina Dahlizar, Ofa Suzanti Betha, Estu Mahanani Dhilasari
|
179-190
|
|
|
Aminah Maryani, Nur Arfa Yanti, La Ode Ahmad Nur Ramadhan, Reza Kurniawan
|
191-199
|
|
|
Halimatussakdiah Halimatussakdiah, Ulil Amna, Vivi Mardina, Misdi Misdi
|
200-216
|
|
|
Rahmawati Rahmawati, Meliana Meliana, Lestia Furnapasta, Syarifa Wahidah Al Idrus, Baiq Fara Dwirani Sofia, Sya’ban Putra Adiguna, Jono Irawan
|
217-227
|
|
|
Siti Mutrofin, Ekantoro Ekantoro, Rurini Retnowati, Hanisah Kamilah
|
228-240
|
|
|
I F Nurcahyo, Fitria Rahmawati, Lisa Agustina Nurlaila, Yuniawan Hidayat, Eddy Heraldy, Khoirina Dwi Nugrahaningtyas, Taufiiq-Yap Yun Hin
|
241-245
|
|
|
Alpan Sofyan Tanjung, Rifda Adillah, Muhammad Fajrul Rahman, Yulia Eka Putri
|
246-253
|
|
|
Eddy Heraldy, Edi Pramono, Yuniawan Hidayat, Khoirina Dwi Nugrahaningtyas, Angel Maydeleine, Intan Dwi Rahmadani
|
254-263
|
|
|
Yulia Theodora Situmorang, Halimatussakdiah Halimatussakdiah, Ulil Amna, Vivi Mardina
|
264-273
|

_(1).jpg)



_50_75_50_75.jpg)

.png)



.png)